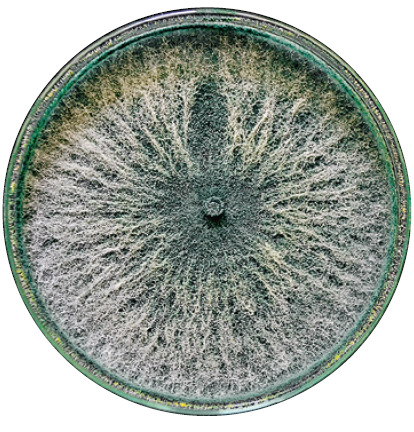

Бактерии, грибы и насекомые-хищники
В российском АПК растет популярность биологических средств защиты растений

Тренд на расширение производства органической, экологически чистой сельскохозяйственной продукции способствует и увеличению использования в растениеводстве различных биометодов для борьбы с болезнями и вредителями. Иногда внедрение БСЗР бывает вынужденным, когда по каким-либо причинам применение агрохимии неоправданно или невозможно. Впрочем, полностью отказаться от химпрепаратов получится не скоро, а вероятнее всего, и никогда. Идеальным подходом эксперты и аграрии считают совмещение в работе химических и биологических средств.
В декабре 2020 года в Европе стартовала программа European Green Deal, основой которой является стратегия From Farm to Fork — «от поля до вилки». Стратегия обозначает ряд целей, в числе которых к 2030 году сократить потребление химических СЗР на 50 %, а также увеличить долю органической продукции до 25 %. Биологизация земледелия становится общемировым трендом. В 2022-м объем продаж биопрепаратов в мире в стоимостном выражении приблизился к $7 млрд, а к 2025-му, согласно прогнозу Exactitude Consultancy, превысит $10 млрд при ежегодных темпах прироста в 17 %.

В российском сельском хозяйстве переход к биозащите также становится одним из драйверов развития. Заместитель директора по научной работе ВНИИ биологической защиты растений Владимир Исмаилов считает, что это хороший стимул для расширения площадей под органику. Данный тренд наблюдают и производители биологических средств защиты растений (БСЗР). Так, по словам руководителя регионального представительства «Юг» компании «Бионоватик» (занимается разработкой, производством и внедрением биотехнологических методов защиты и питания растений) Ивана Лысенко, Россия находится в первой пятерке в мире по объемам использования биопрепаратов. «Страна сильно продвинулась в биологизации растениеводства за прошедшие пять лет», — констатирует он.
Биологические средства защиты растений — это препараты, содержащие в своем составе полезные бактерии (Bacillus subtilis, Pseudomonas fluorescens, Azotobacter chroococcum и др.), грибы (Trichoderma spp. и др.) и их метаболиты, которые выполняют разнообразные функции. БСЗР защищают растения от болезней и вредителей, а также усиливают питание азотом, фосфором, калием и микроэлементами из почвы, повышают устойчивость к холоду, жаре, засухе, переувлажнению и засолению, снижающим урожайность агрокультур.
Российская Стратегия развития органического производства до 2030 года тоже предполагает увеличение использования БСЗР. В ее рамках планируется перевести на органическое земледелие более 4 млн га. Сейчас площади, на которых применяют биосредства защиты, составляют в стране, по разным оценкам, от 655 тыс. до 700 тыс. га.
Исторически в деле внедрения биологических СЗР отечественное растениеводство опережает Запад, где в ХХ веке активно развивалось и совершенствовалось применение системных химикатов. «Биозащита агрокультур не является чем-то новым и эксклюзивным, — утверждает заместитель президента компании «Соевый комплекс» («СОКО») по научной части (специализируется на создании сортов сои для разных регионов России и зарубежья, испытании и продвижении наиболее эффективных препаратов, разработке новых зональных технологий возделывания данной агрокультуры) Александр Слухов. — Если вернуться во времена СССР, где данное направление активно развивалось, то только в РСФСР площадь, защищенная биометодом, превышала 1 млн га». И до сих пор он не утратил своей значимости и активно применяется во многих бывших союзных республиках. В частности, в Узбекистане, где производят хлопчатник и овощи — культуры, которые очень сильно подвержены поражению различными видами вредных насекомых, — биометод используют с успехом и теперь.
Существуют и тормозящие распространение БСЗР факторы. Прежде всего это недостаток осведомленности сельхозпроизводителей, нехватка специальных знаний, из-за чего происходят нарушения технологии и биосредства в итоге оказываются неэффективными, говорит Иван Лысенко. Недоверию агропредприятий способствует печальный опыт применения некачественных биопрепаратов, которые производятся в кустарных условиях, полагает замдиректора по науке НВП «БашИнком» (Башкортостан, разработка, производство и внедрение биопрепаратов для растениеводства и животноводства), доктор биологических наук Владислав Сергеев. «Для выпуска качественных биологических препаратов необходимо наладить производство продукции по технологиям, обеспечивающим асептические условия культивирования, поддержание параметров в автоматическом режиме, входной контроль сырья и приемочный контроль готового продукта», — говорит он.
Организация такого высокотехнологичного производства весьма затратна, поэтому для насыщения рынка качественными препаратами важна поддержка государства. И в частности — заинтересованность региональных властей, акцентирует внимание председатель правления Союза органического земледелия Сергей Коршунов. Они могут на местном уровне помогать продвижению БСЗР организацией мероприятий по обмену опытом, демонстрации посевов.
Гендиректор компании «АгроБиоТехнология» (производит биологические СЗР, производственные мощности — в Белгородской и Московской областях) Денис Морозов соглашается с тем, что внедрение биозащиты могло бы происходить быстрее при более активной государственной поддержке. «Отсутствие субсидий для агропредприятий на биологические СЗР и консультационных центров по внедрению биологической и интегрированной защиты растений — вот это все и задерживает развитие данного направления».
Какие преимущества
Основным преимуществом биологической защиты является ее экологичность. «Микробиологические препараты безопасны для растений, человека, животных и окружающей среды», — перечисляет Сергеев. Помимо этого, биопрепараты часто производят комплексное воздействие на агрокультуру: помимо собственно защиты, они положительно влияют на полезную почвенную микрофлору, повышают иммунитет растений, стимулируют рост, способствуют лучшему усвоению питательных веществ. Тогда как после пестицидных обработок на агрокультурах вследствие стресса наблюдается задержка роста.
Применение биопрепаратов — это и вынужденная мера, добавляет Иван Лысенко. В агрохимии в последние годы не появилось новых действующих веществ (ДВ), а патогены изменяются, приспосабливаются, вырабатывают резистентность. Все, что могут сделать производители агрохимии при создании нового препарата, — смешать несколько известных ДВ в разных пропорциях. «В то же время БСЗР на основе микроорганизмов мутируют каждую секунду, борьба уже происходит, они взаимно приспосабливаются, — рассказывает руководитель. — Полезная бактерия выделяет порядка 60 антибиотиков. Есть патоген, и она “подбирает к нему ключик”, определяет, какой фермент наиболее активен против данного патогена, и вырабатывает больше именно этого фермента».
